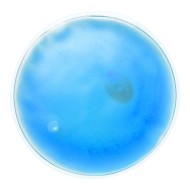
Kison heat pack - AP781012-06

Kison heat pack - AP781012-07
0.68€ (1.34 лв.) with VAT
0.57€ (1.11 лв.)
This product has a minimum quantity of 50
Transparent, reusable heat pack with coloured gel.


- Position:
- I. Front side
- Technology:
- Pad printing (P3)
- Max. number of colours:
- 1
- Max. diameter:
- 50mm

- Position:
- II. Back side
- Technology:
- Pad printing (P3)
- Max. number of colours:
- 1
- Max. diameter:
- 50mm
| Characteristics | |
| Catalogue (Title / Chapter / Page) | COOL 2024 // 443 |
| Colour(s) | green |
| Country of origin | CN |
| Cubage | 0.02525 m3 |
| Declaration of Conformity | Download |
| Description | Transparent, reusable heat pack with coloured gel. |
| EAN code | 5996425552895 |
| Export carton dimensions | 45 x 33 x 17 cm |
| Gross weight | 13 kg |
| Individual product weight | 60 g |
| Inner carton quantity | 50 pcs |
| Item number | AP781012-07 |
| Material(s) | Plastic |
| Net weight | 12 kg |
| Product name | Kisonheat pack |
| Quantity | 200 pcs |
| Size | ø100×10 mm |
| Tariff number | 3926909790 |